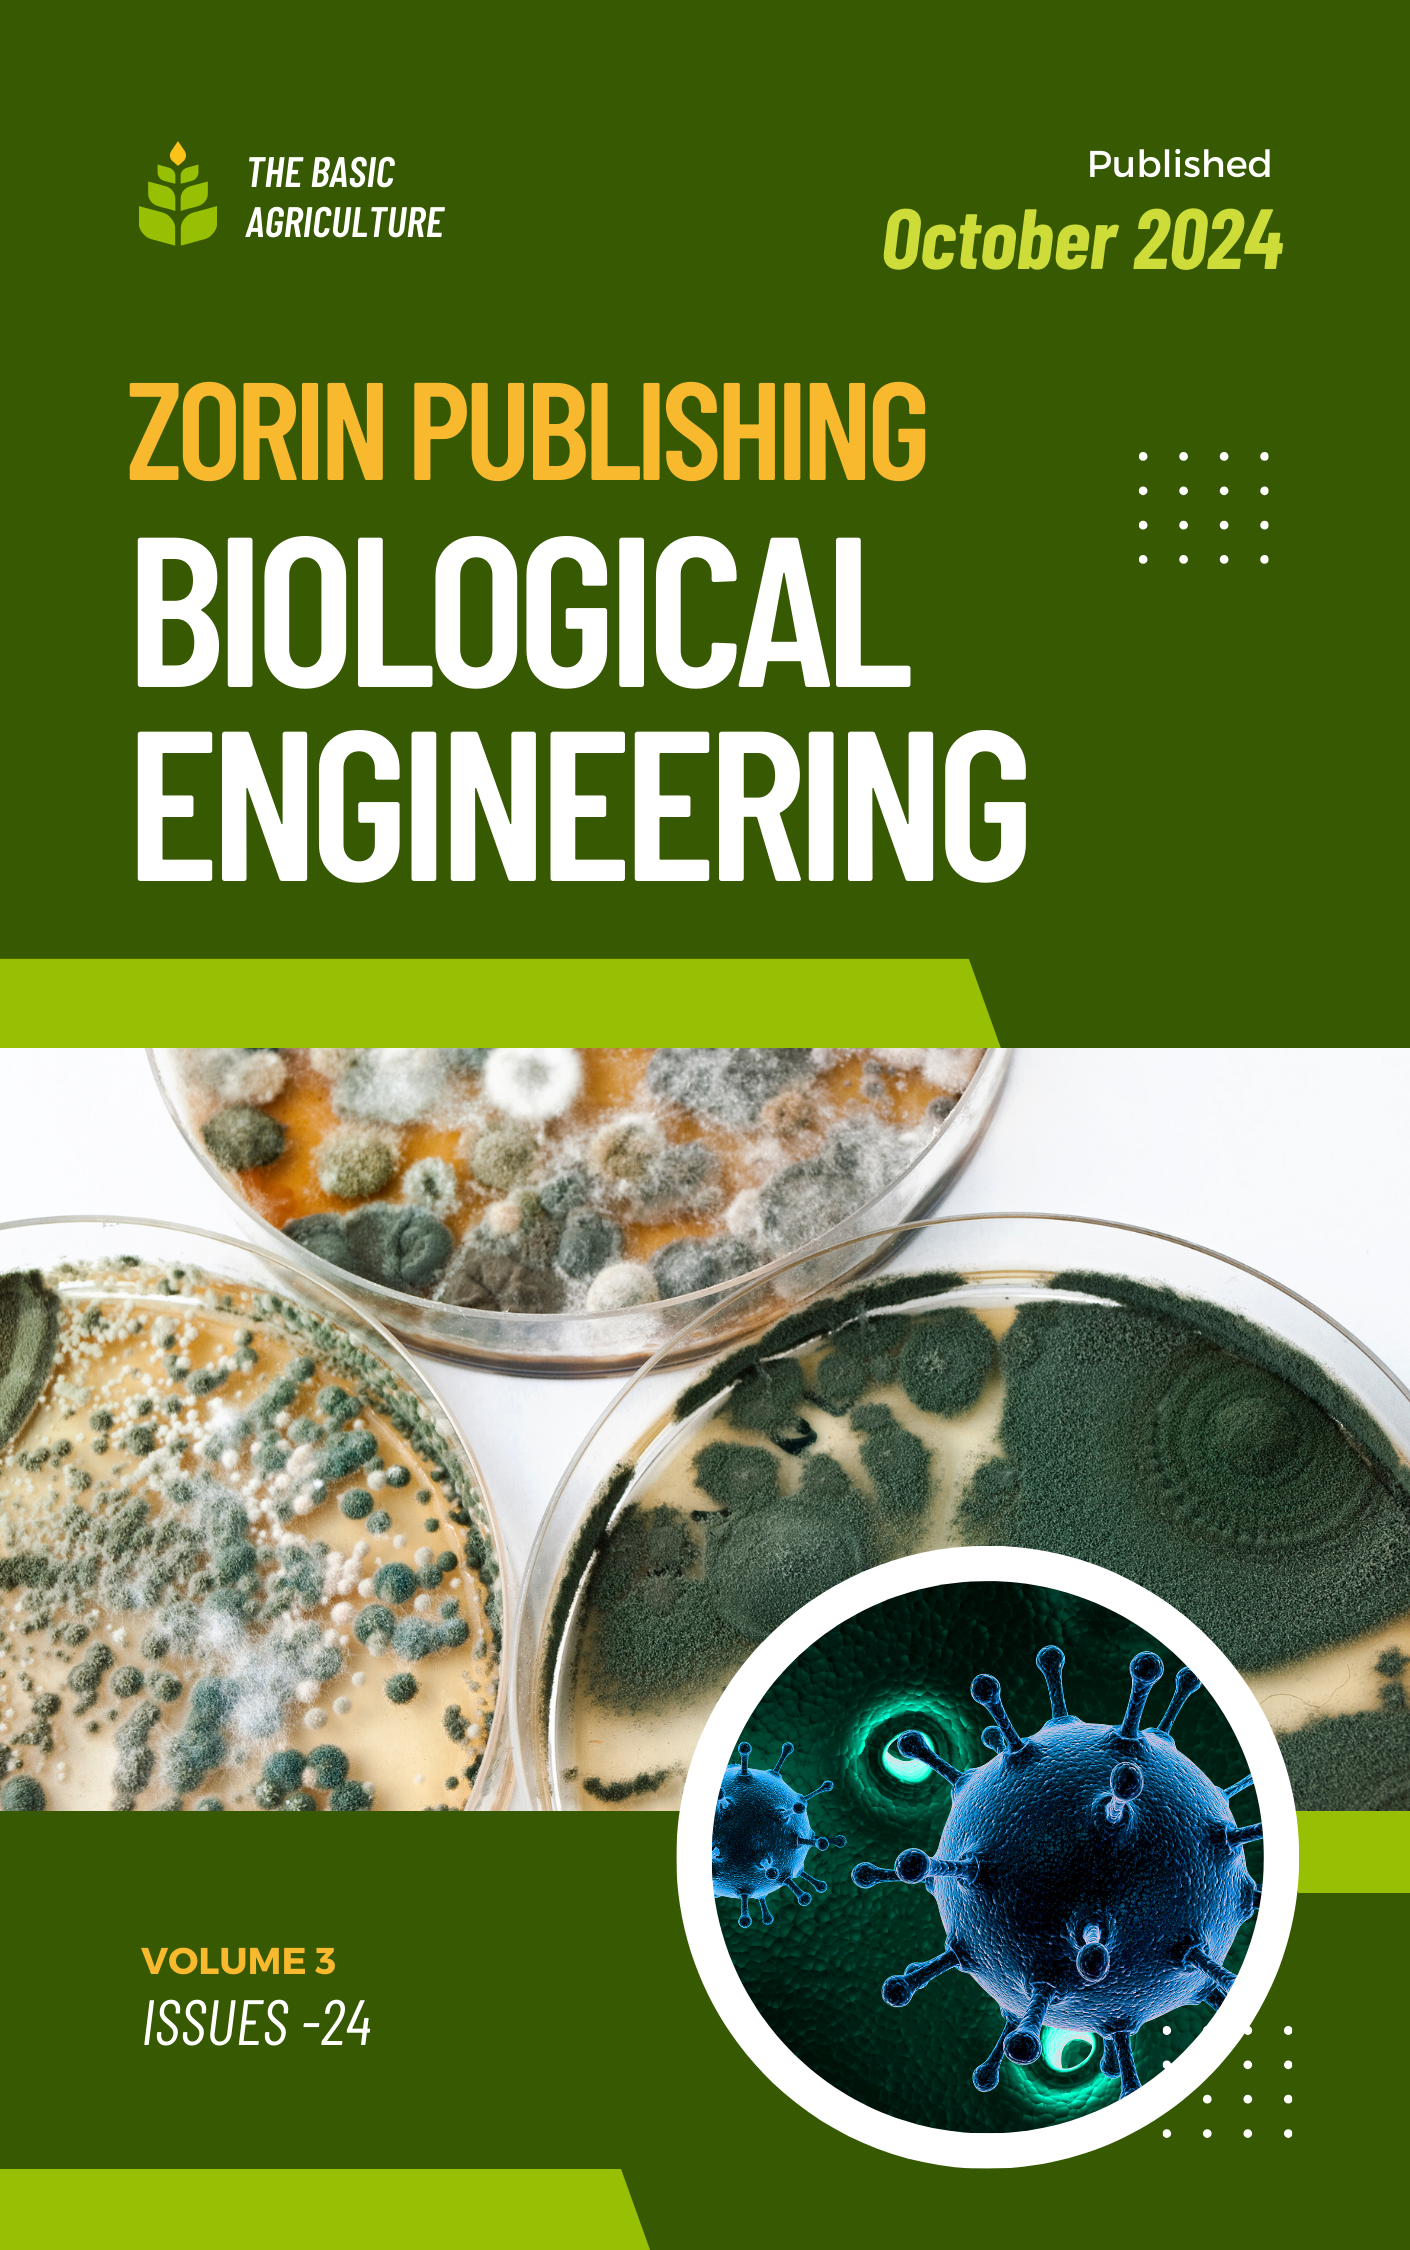

-

 In the ever-evolving world of academia and professional development, journals play a critical role in the dissemination of knowledge, fostering innovation, and promoting intellectual collaboratio.
In the ever-evolving world of academia and professional development, journals play a critical role in the dissemination of knowledge, fostering innovation, and promoting intellectual collaboratio.REPRINTS
Reprints are physical copies of articles published in our journal. They are ideal for authors who wish to distribute their work to colleagues, institutions, or at conferences.EVENTS
Events in academia serve a multitude of purposes. They are not just an avenue for disseminating knowledge but also an important platform for researchers, professionals, and students to interact, collaborate, and innovate.Our Vision
Our vision at Zorin Publications is to be a leading open-access publisher that empowers researchers and promotes the free exchange of knowledge. We aim to bridge the gap between academia and society, ensuring that high-quality scientific information is accessible to all, regardless of their background or resources. Through our commitment to excellence, collaboration, and innovation, we envision a world where scientific discovery fuels progress and enhances the quality of life for individuals and communities worldwide.
Our Journals

"Zorin Journal of Biomedical Engineering & Biotechnology"
At Zorin Publications, our mission is to democratize access to scientific knowledge by providing an inclusive and collaborative platform for researchers, scholars, and educators. We are dedicated to ensuring that everyone has the opportunity to contribute to and benefit from the advancement of scientific research.
Allocation : @10000 / @1000"Zorin Publishers" Online Global Platform

Make an Informed Decision
"Zorin Publishers" offers an open-access medical journal platform, connecting researchers globally. We ensure free, unrestricted access to high-quality scientific research. Our peer-reviewed content supports knowledge sharing across medical fields. Join us in advancing medical science through collaboration and innovation.

Analyze Journals & Researchers
Zorin Publishers provides an open-access platform for medical journals, enhancing research accessibility worldwide. We empower medical professionals with resources to innovate and collaborate. Peer-reviewed content guarantees quality and accuracy. Together, we advance the future of healthcare.

Have an In-Depth View
Zorin Publishers’ medical journal platform brings open access to essential research, uniting the global medical community. We support advancements in healthcare through transparent, peer-reviewed publications. Authors gain visibility, while readers benefit from unrestricted access. Shape the future of medicine with us.

Connecting Researchers Globally
"Zorin Publishers" offers an open-access medical journal platform, connecting researchers globally. We ensure free, unrestricted access to high-quality scientific research. Our peer-reviewed content supports knowledge sharing across medical fields. Join us in advancing medical science through collaboration and innovation.
We Support

Researchers
Zorin Publishers empowers researchers by providing a global platform for publishing peer-reviewed studies, promoting collaboration, and ensuring their findings reach an international audience, enhancing knowledge-sharing and advancing research in various scientific disciplines.
Doctors
Zorin Publishers offers doctors access to recent medical advancements, case studies, and practical resources, supporting evidence-based practices and improving patient care. This resource ensures healthcare professionals are equipped with cutting-edge knowledge.
Academicians
Zorin Publishers enables academicians to access valuable scientific literature, engage in collaborative research, and support students’ growth. Our platform keeps educators current on research trends, fostering future leaders in medical research and healthcare.856Journals and Societies Recommend Zorin Publishers10500Journals Published360Researchers & Academicians Association51Authors Served IN CountriesAdvantages at Zorin
- Broad Range of Journals: We cover a wide variety of disciplines, offering researchers a suitable platform for their work.
- Easy Open Access Compliance: Our platform supports authors in meeting open-access mandates from funding agencies and institutions.
- Simple Online Submission: We provide a user-friendly submission process, making it easy for authors to submit their research.
Our Editorial in Focus
Demetrios A. Spandidos
:
Charis M. Galanakis
:
Eleftherios P. Diamandis
George P. Chrousos